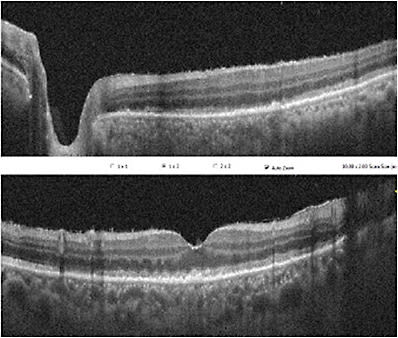
FIGURE 3: OCT of patient in Figure 1. Note mild hyperreflective deposits between RPE and Bruch’s membrane and RPE undulations. IMAGE COURTESY MUSA ABDELAZIZ, MD

Primary vitreoretinal lymphoma (PVRL) is a great masquerader that is often misdiagnosed as uveitis; it is a subset of primary central nervous system lymphoma (PCNSL). In the literature, PVRL at times is not distinguished from other forms of intraocular lymphoma. The term intraocular lymphoma encompasses PVRL and uveal lymphoma. An important distinction between uveal lymphoma and PVRL is the location relative to Bruch’s membrane. Uveal lymphomas are posterior to Bruch’s membrane, while PVRL cells are present anterior to Bruch’s membrane.
PVRL is typically diffuse large B-cell lymphoma in 95% of cases and a minority of cases are T-cell lymphoma.1-3 The exact etiology remains unclear, with multiple theories of an antigenic drive by self or an infectious agent that triggers malignant B-cell expression.1,4 The incidence of PVRL in the United States and Europe has tripled over the past 15 years in both immunocompetent and immunocompromised patients; it is unclear if this is due to increased incidence or improved diagnosis and recognition of the disease.1
The incidence of PVRL is approximately 0.047 cases per 100,000 people per year. It typically presents in the fifth to sixth decade of life with bilateral involvement; if unilateral, bilateral involvement eventually occurs in 60% to 80% of cases.5,6 About one-third of PVRL patients will have concurrent PCNSL at presentation.1,7 The most common presenting symptoms are floaters, blurred vision, and painless vision loss. At initial presentation, 16% to 34% present with CNS involvement, while 15% to 25% of all PCNSL patient have PVRL at presentation. About 65% to 90% of patients with PVRL will develop CNS lesions after 16 to 30 months.5,7-9
CLINICAL FINDINGS
The findings are variable and can be misdiagnosed initially as uveitis. The most common anterior segment findings are anterior chamber cells and keratic precipitates. Posterior findings include vitreous cells, creamy-yellow retinal/subretinal lesions, deep white intraretinal dots, and “leopard skin” pigmentation.
IMAGING
On fundus autofluorescence (FAF) images, lesions appear hyperautofluorescent in leopard spotting and hypoautofluorescent for white lesions above the retinal pigment epithelium (RPE) (Figure 1 and 2).


On optical coherence topography (OCT), PVRL lesions appear as hyperreflective subretinal infiltrates between RPE and Bruch’s membrane, exudative detachment with subretinal hyporeflective fluid, and/or RPE undulations and thickening (Figure 3).
Findings on fluorescein angiography consist of punctate hyperfluorescent window defects, round hypofluorescent lesions, and vasculitis. On indocyanine green angiography the lesions are hypocyanescent in early phase.
DIAGNOSIS
The diagnosis can be elusive and may lead to delay in treatment. On average, it takes 1 year between symptom onset and diagnosis of PVRL.2 The gold standard for diagnosis of PVRL is cytology. The diagnosis is typically made with clinical exam, cytology, and adjunctive testing including flow cytometry and immunohistochemistry. The use of interleukin (IL)-10:IL-6 ratio and detection of myeloid differentiation primary response 88 (MYD88)-L265P mutation have improved the ability to detect PVRL. An IL-10:IL-6 ratio greater than 1.0 is considered to have a higher probability of being PVRL; however, there are cases of non-neoplastic uveitis with elevated IL-10:IL-6 ratios. Cases of T-cell PVRL and PVRL cases with severe sub-RPE or retinal infiltration may not have an elevated ratio.5,10 The MDY88 L265P mutation is reported in 60% to 80% of PVRL cases.5,9
Lymphoma cells can be present in both the anterior chamber and vitreous, and given the lower cellular yield from the aqueous, a vitreous biopsy is preferred. The biopsy is completed using standard vitrectomy with low cut rate (600 to 1,500 cuts per minute) and low aspiration due to the fragility of lymphoma cells.11
Our method from vitreous biopsy using vitrectomy: prime the machine and turn the infusion to air to clear the line of fluid. Fluid in the cutter line is aspirated using the foot-pedal. A red-top serum tube is placed in sterile bags and two 18-gauge needles are placed in the top of the tube. The return line on the vitrectomy cutter is disconnected and using a connector, the red-top tube is connected to the two return lines of the cutter (Figure 4). The vitreous biopsy is completed under air. Once an undiluted sample is obtained, the red-top tube is removed and replaced with a new tube. The biopsy is repeated under fluid to obtain a diluted sample.

It is important to coordinate with the pathologist prior to the biopsy, as lymphoma cells undergo morphological degradation within 60 minutes of biopsy. Samples that require delivery should be placed in Roswell Park Memorial Institute (RPMI) solution or other medium per the pathologist.2,3,12
TREATMENT
There are multiple treatment paradigms depending on the institution. One approach is to treat with systemic chemotherapy regardless of CNS status.13 Another approach is to treat based on extent of disease.2 For ocular treatment, the options include therapeutic vitrectomy, intravitreal methotrexate, intravitreal rituximab, and intravitreal melphalan. For patients with bilateral eye involvement at presentation, the use of systemic therapy with high dose methotrexate should be considered.2 In a retrospective, multicenter study, the treatment of PVRL with systemic chemotherapy was associated with a lower risk of developing CNS lymphoma.14 In other studies, treatment with systemic therapy regardless if unilateral or bilateral disease was associated with lower risk of CNS involvement.13,14 Ocular radiation is typically used as salvage therapy. For PVRL without systemic involvement, systemic monitoring by a hematologist-oncologist should be coordinated with MRI of the brain.
PROGNOSIS
Approximately 90% of PVRL cases will develop CNSL.3,15 Mortality ranges from 9% to 81% in follow-up periods ranging from 12 to 35 months, and retrospective review reported a 5-year survival rate of 41.4%.1,16 For patients with PVRL diagnosed before CNS involvement, there is a survival advantage of 60 months versus 35 months.17 For patients with PCNSL with ocular involvement, the median progression-free survival is 18 months and overall survival of 31 months. Ocular therapy improves local tumor control but has no effect on survival.8 NRP
REFERENCES
- Sagoo MS, Mehta H, Swampillai AJ, et al. Primary intraocular lymphoma. Surv Ophthalmol. 2014;59(5):503-516. doi:10.1016/j.survophthal.2013.12.001
- Pulido JS, Johnston PB, Nowakowski GS, Castellino A, Raja H. The diagnosis and treatment of primary vitreoretinal lymphoma: a review. Int J Retina Vitreous. 2018;4(1). doi:10.1186/s40942-018-0120-4
- Coupland SE, Damato B. Understanding intraocular lymphomas. Clin Exp Ophthalmol. 2008;36(6):564-578. doi:10.1111/j.1442-9071.2008.01843.x
- Shen DF, Herbort CP, Tuaillon N, Buggage RR, Egwuagu CE, Chan CC. Detection of toxoplasma gondii DNA in primary intraocular B-cell lymphoma. Mod Pathol. 2001;14(10):995-999. doi:10.1038/modpathol.3880424
- Carbonell D, Mahajan S, Chee SP, et al. Consensus recommendations for the diagnosis of vitreoretinal lymphoma. Ocul Immunol Inflamm. 2021;29(3):507-520. doi:10.1080/09273948.2021.1878233
- Venkatesh R, Bavaharan B, Mahendradas P, Yadav NK. Primary vitreoretinal lymphoma: prevalence, impact, and management challenges. Clin Ophthalmol. 2019;13:353-364. doi:10.2147/OPTH.S159014
- Sobolewska B, Chee SP, Zaguia F, et al. Vitreoretinal lymphoma. Cancers. 2021;13(16). doi:10.3390/cancers13163921
- Grimm SA, McCannel CA, Omuro AMP, et al. Primary CNS lymphoma with intraocular involvement: international PCNSL collaborative group report. Neurology. 2008;71(17):1355-1360. doi:10.1212/01.wnl.0000327672.04729.8c
- Santos MC, Jiang A, Li AS, Rao PK, Wilson B, Harocopos GJ. Vitreoretinal lymphoma: optimizing diagnostic yield and accuracy. Am J Ophthalmol. 2021;236:120-129. doi:10.1016/j.ajo.2021.09.032
- Akpek EK, Foster CS. Primary intraocular lymphoma with a low interleukin 10 to interleukin 6 ratio and heterogeneous IgH gene arrangement. Arch Ophthalmol. 2000;118(5):731-732.
- Jiang T, Zhao Z, Chang Q. Evaluation of cytologic specimens obtained during experimental vitreous biopsy using B-cell lymphomal. Eur J Ophthalmol. 2014;24(6):911-917. doi:10.5301/ejo.5000488
- Whitcup SM, Chan CC, Buggage RR, Nussenblatt RB, Byrnes GA, Rubin BI. Improving the diagnostic yield of vitrectomy for intraocular lymphoma. Arch Ophthalmol. 2000;118(3):446.
- Damato B, Bever GJ, Kim DJ, Afshar AR, Rubenstein JL. An audit of retinal lymphoma treatment at the University of California San Francisco. Eye (Lond). 2020;34(3):515-522. doi:10.1038/s41433-019-0539-3
- Dalvin LA, Pulido JS, Shields CL, et al. Vitreoretinal lymphoma: central nervous system lymphoma risk with unilateral or bilateral ocular tumour. A multicentre collaboration. Eye (Lond). 2022;10.1038/s41433-021-01887-2. doi:10.1038/s41433-021-01887-2
- Mashayekhi A, Dalvin LA, Lim LS, et al. Association of vitreoretinal lymphoma with systemic lymphoma. Retina. 2021;41(2):259-265. doi:10.1097/IAE.0000000000002855
- Ahmed AH, Foster CS, Shields CL. Association of disease location and treatment with survival in diffuse large B-cell lymphoma of the eye and ocular adnexal region. JAMA Ophthalmol. 2017;135(10):1062. doi:10.1001/jamaophthalmol.2017.3286
- Hormigo A, Abrey L, Heinemann MH, DeAngelis LM. Ocular presentation of primary central nervous system lymphoma: diagnosis and treatment. Br J Haematol. 2004;126(2):202-208. doi:10.1111/j.1365-2141.2004.05028.x








